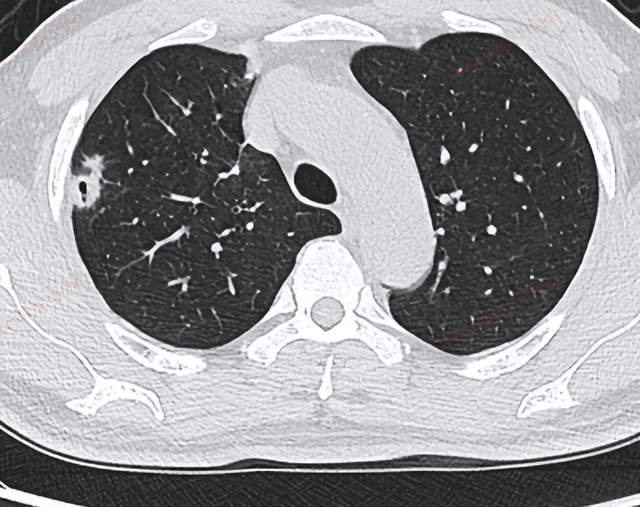

2022年即将过去三~分~之~一~
疫情防控仍然是生活中的必修课
学分未修满,学时不可知
课程收获是:
保持危机意识, 切实付出行动
强身健体,增强疾病防治认识 ,健康面临的险恶敌人,远远不止新冠...
据2020年浙江省监测数据显示:癌症是浙江省居民死亡的第1位死因。处于前5位的恶性肿瘤为肺癌、肝癌、胃癌、大肠癌、胰腺癌,占恶性肿瘤死亡数的68.34%。

2022年4月15日至21日是第28个全国肿瘤防治宣传周,今年宣传周的主题是:癌症防治早早行动。
旨在积极倡导每个人做自己健康的第一责任人,正确认识癌症、积极防控癌症,践行健康文明的生活方式。

每5人中就有1人将在其一生中患癌症;
每8名男性、每11名女性中就有1人将因癌症而死亡;
乳腺癌成为全球最常见癌症;
肺癌仍是死亡人数最多的癌症。
防癌抗癌早筛早诊, 将会提高生存率,降低死亡率。主动参加防癌健康体检,做到
早预防、早发现、早诊断、早治疗

肿瘤的发生和发展是一个漫长的过程,很多患者早期没明显的临床症状,70%以上患者一确诊便是中晚期。因此,肿瘤的早筛早诊极其重要。
癌症的“三级预防”是重要措施:

一级预防 指病因预防,尽量避免或减少危险因素暴露,降低癌症发病风险;
二级预防 指对高危人群进行早期筛查、早期诊断和早期治疗,提高癌症治愈率和生存率,降低癌症死亡率;
三级预防 指通过合理治疗和康复,缓解癌症患者症状,提高生存率和生存质量。
主动参加防癌健康体检 ,积极践行二级预防。PET/CT是现在先进的肿瘤诊断方法,一次检查扫描获得全身各方位断层图像,能准确地检出恶性肿瘤及其全身的转移灶,并且能够准确地对肿瘤分期,因此,PET/CT也有肿瘤界的“福尔摩斯”之称。

被PET/CT“现代医学高科技之冠”的盛誉所吸引,小编找到几个PET/CT病例,患者是在平安健康(检测)中心 接受了全身PET/CT检查,在这些肿瘤疑似患者和有癌前病变的人群中,PET/CT有效发现早期病变、实现病灶的精确定位。看官们一起来看看吧!
病例1
肺部结节患者行PET/CT发现肾脏肿瘤
男性,61岁
相关病史: 夜间盗汗,肺部结节性质待查,在平安健康(检测)中心 接受PET/CT检查。
CT肺部平扫图像
双肺散在多发结节,部分结节内见空洞形成。
PET/CT影像学表现

肺部结节广泛摄取,且左肾上极疑似环形代谢增高,与尿液摄取重叠,影像诊断。

大量饮水、排尿,反复多次,两小时后再次扫描:

PET/CT结论与病理结果对比
PET/CT结论:
左肾上极环形代谢增高影,CT未见异常密度,考虑肾癌,建议临床进一步检查。双肺多发类圆形结节、结片影,部分含空洞,代谢不同程度增高,考虑转移瘤。
肺部结节穿刺病理结果:
肺低分化肉瘤样癌,肾来源性。
对比结论:
PET-CT实现肿瘤的精准定位及确诊。
病例2
PET/CT检查卵巢癌
女性,60岁
相关病史:宫颈高级别鳞状上皮内病变(HSIL)锥切术后4月;否认结核及其他慢性病史。无其他临床症状。已绝经,无外伤史。2021-3-21日,患者因检查发现CA125渐进升高(250U/mL)后,在平安健康(检测)中心接受PET/CT检查。
PET/CT影像学表现




结论: 盆腔双附件区结节灶(左侧著)、右侧膈前上、肝脏包膜及腹盆腔多发结节灶、腹膜后多发淋巴结FDG代谢增高,考虑:卵巢癌(源于左侧卵巢可能性大)并上述部位多发转移瘤
PET/CT结论与病理结果对比
PET/CT结论:
考虑:卵巢癌(源于左侧卵巢可能性大)
手术病理结果:
卵巢癌
对比结论:
PET-CT实现肿瘤的精准定位及确诊。
病例3
可疑肝转移患者PET/CT发现原发灶
男性,78岁
相关病史:一直觉得腹部疼痛,在基层医院CT检查,发现肝脏多发低密度灶,怀疑为肝脏多发转移。之后患者在平安健康(检测)中心接受PET/CT检查。
PET/CT影像学表现

上图为肝脏的横断位、冠状位及矢状位图像,依次为PET图像、CT图像、融合图像。图示肝脏体积稍增大,肝内弥漫分布大小不等类圆形低密度灶,部分相互融合,边界不清 ,相应部位放射性摄取明显增高,SUV最大值8.50。

上图显示横断位示胃充盈佳,胃体小弯侧增厚,相应部位放射性摄取异常增高,SUV最大值6.29。

上图中冠矢状位也清楚地显示胃体小弯侧的增厚及FDG代谢的增高。
PET/CT找出原发灶
最后PET/CT诊断为胃癌伴肝脏多发转移,给临床指明了方向,可以制定更针对性的治疗方案。
病例总结
查找原发灶及肿瘤分期
01 PET/CT有效揪出原发灶
对于转移瘤查找原发灶的临床场景,传统影像检查的检出率远远不如PET/CT。PET/CT通过一次采集、全身显像,能同时提供病变部位的详细解剖信息及代谢信息,为肿瘤的诊断、分期及治疗监测提供更具临床价值的信息。
02 PET/CT有效探出早期病变
早期肿瘤病变,可能只有代谢的异常而无明显解剖变化,因此,CT和MRI则不能检出病灶。而若病变的大小及形态发展到一定程度时,往往已经处于疾病晚期。PET/CT可以从分子代谢水平判断疾病特征,只要组织代谢出现异常,便可清晰显示。FDG-PET/CT在卵巢癌的初筛和盆腔良恶性肿物中鉴别作用的准确度(92.1%)显著高于盆腔B超(83.0%)、CT或者磁共振。
03 PET/CT有效评出肿瘤恶性程度
PET/CT是肿瘤界的“福尔摩斯”,对肿瘤良、恶性的鉴别诊断,准确性也高于其他检查手段,总体正确率大于95%。通过肿瘤代谢高低,还可以进行肿瘤术前分期、治疗后肿瘤疗效评估及再分期,可准确指导临床进行下一步治疗,避免不适当的治疗方式,有助于提高患者生存时间和质量。
特别是对于肿瘤疑似患者,或者出现癌前病变的人群,进行PET/CT检查,可以更早发现前期病变,及时预防。
总结——防癌管理,从我做起
俗话说“活到老,学到老”,对于健康管理意识和疾病的防护意识,也是通用的。医学技术在不断发展,我们也要为自己的健康付出实际的管理行动。从当下开始,搜索小程序“中国居民癌症防控行动”,可参与癌症风险自测~


怎么样,你有勇气查看你的测评报告吗?



